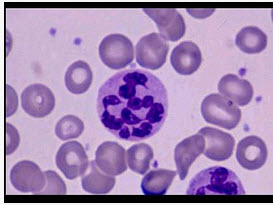

早期缺铁性贫血多为()
A . 正细胞正色素性贫血
B . 小细胞正色素性贫血
C . 小细胞低色素性贫血
D . 大细胞低色素性贫血
E . 大细胞性贫血
[单选题]早期缺铁性贫血多为()A .正细胞正色素性贫血B .小细胞正色素性贫血C .小细胞低色素性贫血D .大细胞低色素性贫血E .大细胞性贫血
[单选题]早期缺铁性贫血的形态学多为()A . 小细胞正色素性贫血B . 小细胞低色素性贫血C . 正细胞正色素性贫血D . 大细胞性贫血E . 大细胞低色素性贫血
[单选题]早期缺铁性贫血的形态学多为()。A . 小细胞正色素性贫血B . 正细胞正色素性贫血C . 小细胞低色素性贫血D . 大细胞低色素性贫血E . 大细胞性贫血
[单选题]早期缺铁性贫血的形态学多为A.小细胞正色素性贫血B.小细胞低色素性贫血C.正细胞正色素性贫血D.大细胞性贫血E.大细胞低色素性贫血
[单选题]缺铁性贫血早期的细胞形态学表现多为()A.小细胞低色素性贫血B.正常细胞正常色素性贫血C.大细胞低色素性贫血D.小细胞正常色素性贫血E.大细胞性贫血
[单选题]缺铁性贫血早期的细胞形态学表现多为()A .小细胞低色素性贫血B .正常细胞正常色素性贫血C .大细胞低色素性贫血D .小细胞正常色素性贫血E .大细胞性贫血
[单选题]缺铁性贫血早期的细胞形态学表现多为()A . 小细胞低色素性贫血B . 正常细胞正常色素性贫血C . 大细胞低色素性贫血D . 小细胞正常色素性贫血E . 大细胞性贫血
[单选题]缺铁性贫血患者,外周血涂片红细胞多为A.正常色素性红细胞B.低色素性红细胞C.高色素性红细胞D.嗜多色性红细胞E.碱性点彩红细胞
[单选题]缺铁性贫血患者,外周血涂片红细胞多为A.正常色素性红细胞B.低色素性红细胞C.高色素性红细胞D.嗜多色性红细胞E.碱性点彩红细胞
[单选题]缺铁性贫血患者,外周血涂片红细胞多为()A . 正常色素性红细胞B . 低色素性红细胞C . 高色素性红细胞D . 嗜多色性红细胞E . 碱性点彩红细胞